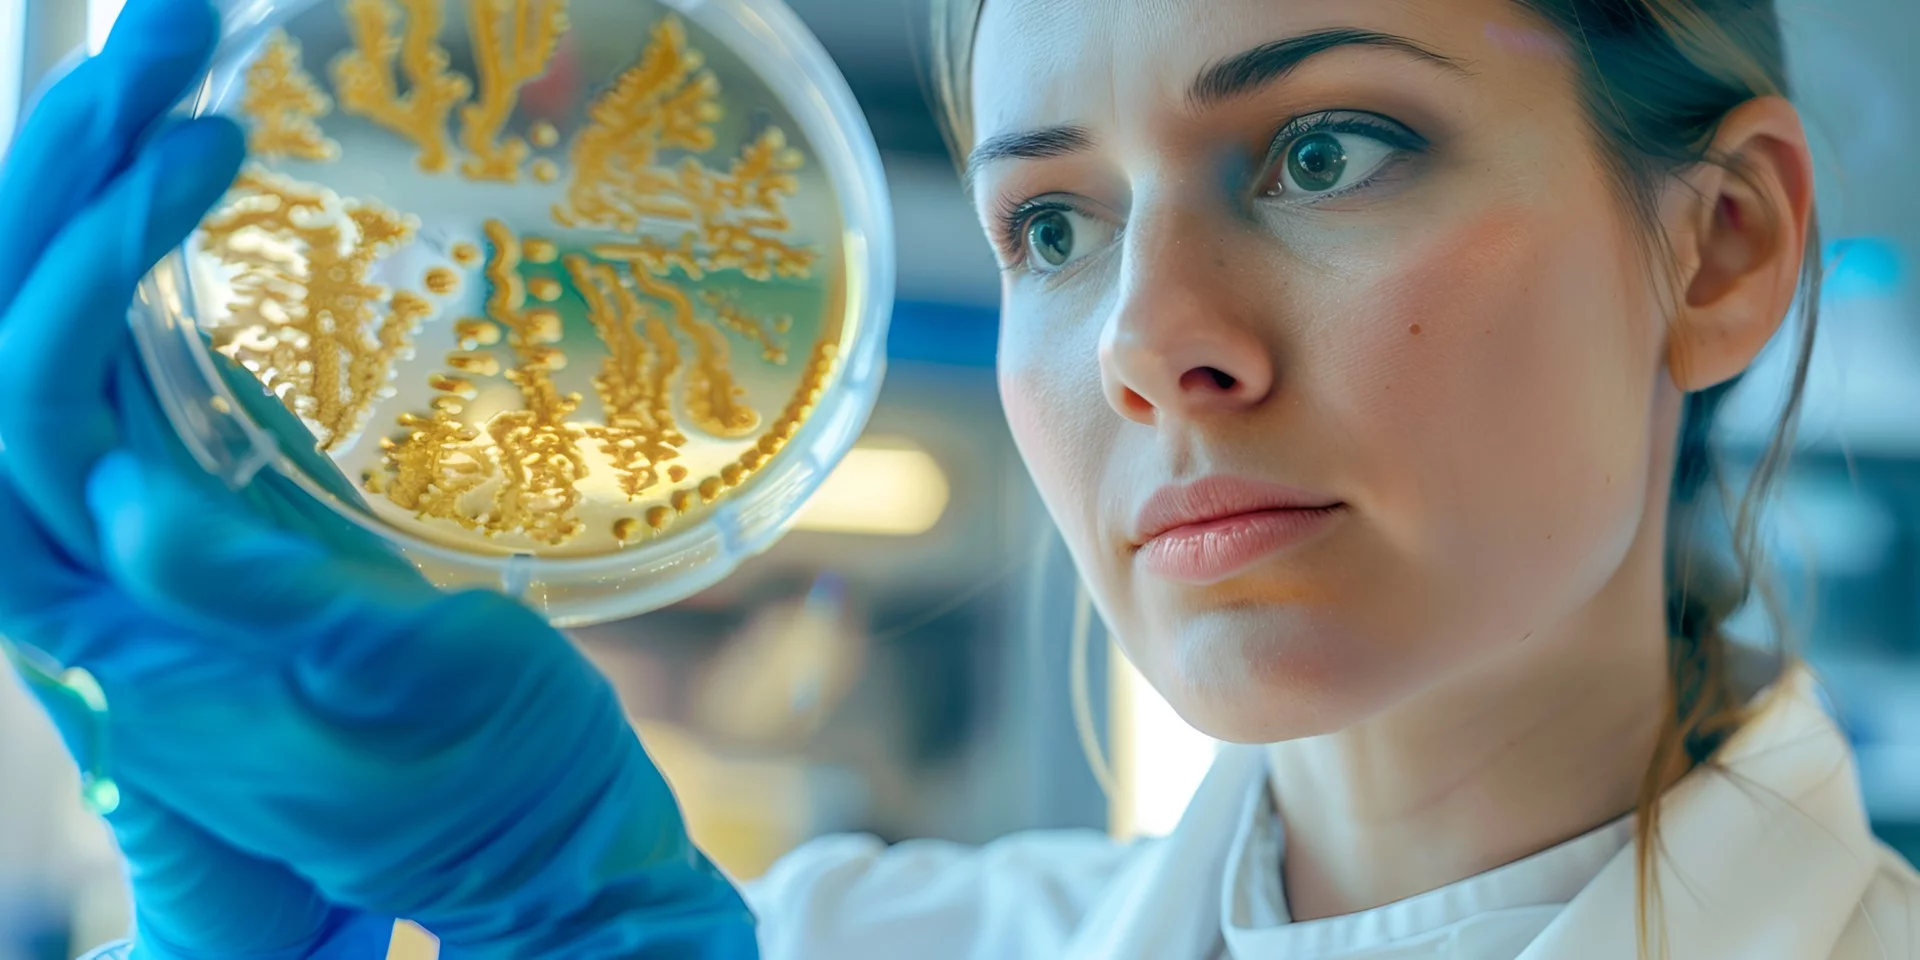
Wissenschaftlerin, die eine Bakterienkultur betrachtet.

Biofilm
Der Begriff Biofilm hat bereits seit einigen Jahren Einzug in den Sprachgebrauch der Hygieniker und Anwendungstechniker gefunden. Biofilme sind komplexe Lebensgemeinschaften von Mikroorganismen, die überwiegend in Wassersystemen vorkommen. Diese Biofilme sind ubiquitär, d.h. sie kommen überall vor. Dabei gleicht kein Biofilm dem anderen. Das Zusammenspiel der einzelnen Substanzen und der Mikroorganismen in diesen Biofilmen ist sehr komplex und es herrscht eine hohe Diversität. In der Regel sind solche Biofilme nicht sichtbar, denn sie befinden sich in Rohrleitungen, Schläuchen bzw. an allen wasserführenden Oberflächen. Ausgeprägte Biofilme sind jedoch als Schleimschicht erkennbar. Biofilme ändern sich ständig. Die Gefahr besteht darin, dass sich in den vorhandenen Biofilm Krankheitserreger einnisten, sich dort vermehren und dann ausbreiten. Ob dies geschieht und wie dies geschieht, ist höchst unterschiedlich und ist Gegenstand der laufenden Forschung. Eines ist jedoch klar, Biofilme dienen der Überlebensstrategie: sie schützen die darin lebenden Organismen vor äußeren Einflüssen wie Temperatur, Desinfektionsmittel oder ähnlichem. In diese evolutionäre Überlebensstrategie passt nachfolgend beschriebenes Phänomen bzw. ein Begriff, den die Forschung bereits seit Jahren kennt, der jedoch Vielen noch nicht geläufig ist: der sogenannte VBNC-Zustand.
VBNC
VBNC steht für “viable but nonculturable” und bezeichnet den Zustand, den Mikroorganismen einnehmen können, bei dem sie überlebensfähig, aber mit kulturellen Methoden nicht nachweisbar sind. In diesem Zustand sind die Bakterien – so wird vermutet – nicht vermehrungsfähig und auch nicht infektiös. Die Bakterien sind jedoch in der Lage, diesen Zustand wieder zu verlassen:
„Dieses Phänomen könnte eine Reihe von Beobachtungen aus der Praxis erklären, bei denen es wiederholt zu neu auftretenden Kontaminationen des Trinkwassers kommt (…). Organismen im VBNC-Zustand könnten damit ein erhebliches und bisher unterschätztes Risiko für die hygienische Sicherheit von Trinkwasser darstellen.“,
so eine der Thesen des Verbundprojekts Biofilm-Management der Universitäten Duisburg-Essen, Berlin und Bonn sowie der DVGW-Forschungsstelle TU Hamburg-Harburg und des IWW Zentrum Wasser, Mülheim im Jahre 2014. Der VBNC-Zustand kann zu einer Unterschätzung der Anwesenheit von hygienisch relevanten Mikroorganismen und zu einer Überschätzung der Effektivität von Sanierungsmaßnahmen führen.
„ …Organismen im VBNC-Zustand könnten damit ein erhebliches und bisher unterschätztes Risiko für die hygienische Sicherheit von Trinkwasser darstellen… “
Der VBNC Zustand kann bei verschiedenen Bakterien u.a. Legionellen pneumophilla und Pseudomonaden aeruginosa ausgelöst werden. Dies kann durch verschiedene „Stressfaktoren“ wie ungünstiger pH-Wert, Nährstofflimitierung, Kupferakkumulation, biologische Konkurrenz, aber auch durch Hitze oder zu geringer Dosierung von Desinfektionsmitteln ausgelöst werden. So ist zum Beispiel bereits nachgewiesen, dass eine Dosierung von 2 mg/L Chlor dazu führen kann, dass bei P. aeruginosa der VBNC-Zustand ausgelöst werden kann. (1)
Aktuell ist im Zusammenhang mit Desinfektionsmitteln zur Wasserbehandlung auch eine Anwendung im Bereich von Prüfständen für Wasserzähler relevant. Hierbei stellte sich die Frage, inwieweit die Sanosil Produkte eine Wirksamkeit gegen P. aeruginosa zeigen, wie nachhaltig diese Wirkung ist und welche Rolle in diesem Zusammenhang ggf. nicht-kultivierbare P. aeruginosa (VBNC-Zustand) spielen.
(1) Bédard et. Al, 2014